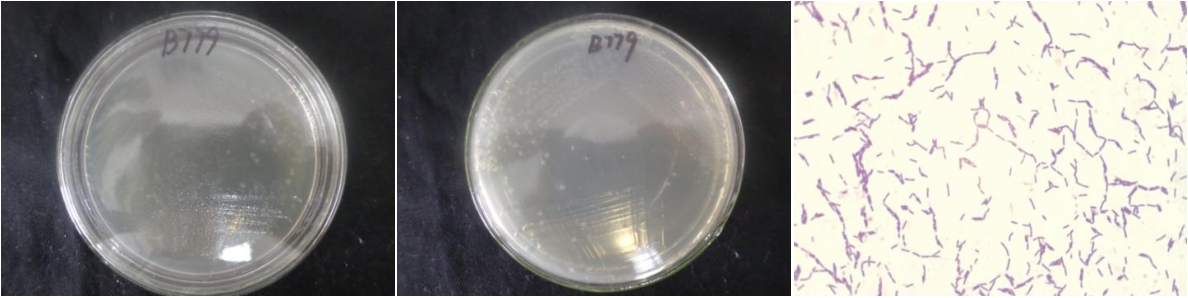

Loading...
| StrainNO | B779 |
| Classification | Bacillus |
| 16s rDNA sequence | CACTCTGTCACCTTAGGCGGCTGGCTCTCTTGCGAGTTACCCCACCGACTTCGGGTGTTACAAACTCTCGTGGTGTGACGGGCG GTGTGTACAAGGCCCGGGAACGTATTCACCGCGGCATGCTGATCCGCGATTACTAGCGATTCCAGCTTCATGTAGGCGAGTTGC AGCCTACAATCCGAACTGAGAGTGGTTTTATGGGATTGGCTCGACCTCGCGGTTTTGCTGCCCTTTGTACCACCCATTGTAGCA CGTGTGTAGCCCAGGTCATAAGGGGCATGATGATTTGACGTCATCCCCACCTTCCTCCGGTTTGTCACCGGCAGTCACCTTAGA GTGCCCAACTGAATGCTGGCAACTAAGATCAAGGGTTGCGCTCGTTGCGGGACTTAACCCAACATCTCACGACACGAGCTGACG ACAACCATGCACCACCTGTCACTCTGTCCCCCGAAGGGGAACGCCCTATCTCTAGGGTTGTCAGAGGATGTCAAGACCTGGTAA GGTTCTTCGCGTTGCTTCGAATTAAACCACATGCTCCACCGCTTGTGCGGGCCCCCGTCAATTCCTTTGAGTTTCAGCCTTGCG GCCGTACTCCCCAGGCGGAGTGCTTAATGCGTTTGCTGCAGCACTAAAGGGCGGAAACCCTCTAACACTTAGCACTCATCGTTT ACGGCGTGGACTACCAGGGTATCTAATCCTGTTTGCTCCCCACGCTTTCGCGCCTCAGTGTCAGTTACAGGCCAAAGAGTCGCC TTCGCCACTGGTGTTCCTCCACATCTCTACGCATTTCACCGCTACACGTGGAATTCCACTCTTCTCTCCTGCACTCAAGTCTCCCAGTTTCCAATGACCCTCCCCGGgTTGARSCGGGGGCTTTCACATCAGACTTAAGAGACCACCTGCGCGCGCTTTACGCCCAAT AATTCCGGACAACGCTTGCCACCTACGTATTACCGCGGCTGCTGGCACGTAGTTAGCCGTGGCTTTCTGGTTAGGTACCGTCAA GGTACCGGCAGTTACTCCGGTACTTGTTCTTCCCTAACAACAGAGTTTTACGATCCGAAAACCTTCATCACTCACGCGGCGTTG CTCCGTCAGACTTTCGTCCATTGCGGAAGATTCCCTACTGCTGCCTCCCGTAGGAGTCTGGGCCGTGTCTCAGTCCCAGTGTGG CCGATCACCCTCTCAGGTCGGCTACGCATCGTCGCCTTGGTGAGCCGTTACCTCACCAACTAGCTAATGCGCCGCGGGCCCATC TATGAGTGATAGCCGAAACCATCTTTCAACTTCTCTACATGAGTAGAAAAGAATTATCCGGTATTAGCCCCGGTTTCCCGGAGT TATCCCAGTCTCATAGGCAGGTTGCCCACGTGTTACTCACCCGTCCGCCGCTAAAATTTAAAAGCAAGCTTTTAAATTTCCGCT CGACTTGCATGTATAGCACGCCGCCCTTCCC |
| Strain Morphology Photos | |
| Morphological Description | The morphology of Colony round;lychee white;edge neatly;steamed bun shaped;wrinkled;slippy;sticky;waxy;The morphology of strain:Rod;having spore;bias in budding spores |